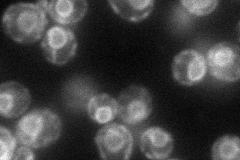
YGR199W
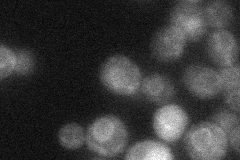
YGR199W
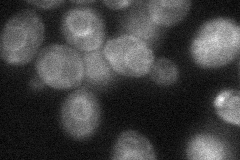
YGR199W
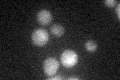
YGR199W
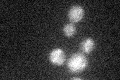
YGR199W

View description
Protein O-mannosyltransferase, transfers mannose from dolichyl phosphate-D-mannose to protein serine/threonine residues of secretory proteins; reaction is essential for cell wall rigidity; member of a family of mannosyltransferases
Localization:
Intensity:
Fold change:
Significance:
-
C’ GFP library in SD

below threshold16.78 -
N' NOP1pr-GFP in SD
ER80.6444 -
N' TEF2pr-mCherry in SD

ER112.38 -
N' NATIVEpr-GFP in SD
ER29.226 -
N' TEF2pr-VC and Cyto-VN in SD
ER37.8138 -
C’ GFP library in SD+DTT
cytosol14.460.86No -
C’ GFP library in SD+H2O2
cytosol15.940.94No -
C’ GFP library in Starvation Media

cytosol16.380.97No -
C’ GFP library on the background of Pup2-DaMP

below threshold -
C’ GFP library on the background of CCT mutant

below threshold15.2290.906884No
